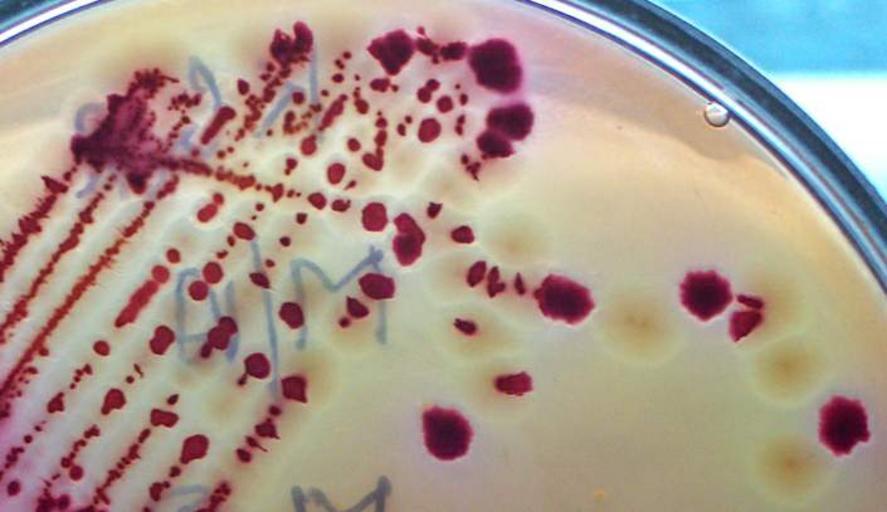

MAKE A MEME
View Large Image
| View Original: | Macconkey LF NLF.jpg (705x407) | |||
| Download: | Original | Medium | Small | Thumb |
| Courtesy of: | commons.wikimedia.org | More Like This | ||
| Keywords: Macconkey LF NLF.jpg en Lactose fermenting pink and non-lactose fermenting colonies seen on MacConkey's agar own Microrao JJMMC Davangere Karnataka India Petri dishes cultures J J M Medical College Bacterial growth medias and tests | ||||